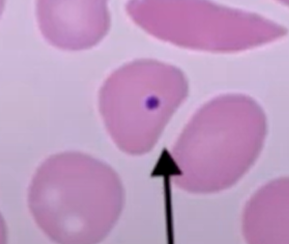
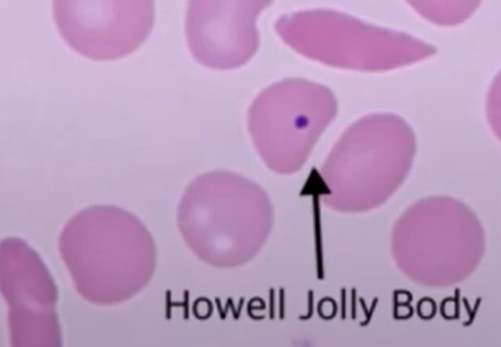

왜 extravascular hemolysis 땐 hemoglobinemia or hemoglobinuria 가 없나 ?
Machrophage가 이 recticular system 의 일부라서 RBC를 삼킨다음 어떻게 하므로 heme이 새나가지 않는다.

most of the hemolytic anemia 는 normo/ micro/ macro?
시험엔 그냥 normo로 외워라.

왜 RBC에 흠이 나거나 하면 Recticuclar system에서 hemolysis 되나
응 저 망 같은걸 squeeze 하면서 원래 RBC는 지나가는데 흠있는 녀석은 터져버림.
ONly dz with high MCHC?
spherocytosis
splenomegaly 의 75% 는 spherocytosis 이다.
다른 anyother hemolytic anemia 보다 훨씬 더 저명
congenital spherocytosis 때 fetus 에 나타나는 병?
hydrops fetalis d/t anemia and following high cardiac output=> total body edema

extravascular hemolysis 때 bilirubin/ Rc / LDH/ jaundice?
목에 collar 없는 unconjugated billi goat 가 높고, urobili도 높고, juandice 잠바 있고, 티백 Rect도 높고, LDH 밀크도 높네.

extravascular 과 intravascular hemolysis 때 splenomegaly/ hepatomegaly/ urine Heme/ hemoglobinemia ?는 ?
extravascular 에서, 특히 spherocytosis 에서 splenomegaly 가 더 심하다…. 하지만 만성에선 모두 splenomegaly 가 존재 할수 있다. 왜? extravascular hematopoiesis 때문에!!
하지만 Macrophage가 처리하는 extravascular 에선 heme이 나올수 없으므로 hemoglobulinemia & hemoglobuliuria 는 intravascular에서만
그리고 hepatomegaly는 모두 존재 Unconjugated bil 를 소화하느라.

hemoglobin 은 너무 작아서 혈중에 있으면 globulin을 통과해서 hemoglobulinuria만든다. 이게 너무 많으며ㅑㄴ?
coca cola urine 을 넘어 convoluted tubule에 막희도록 쌓임 => ATN
rhamdomylolysis 때도 마찬가지. myoglobin 이 흘러나와서 막는다.
그래서 허리가 아파진다.
urobilinogen 은 어째서 intra/extra hemolysis 때 모두 소변에서 증가하나?
둘다 unconj bil 이 많아지므로 그게 간에서 bile duct 로 GI쪽으로 분비 (그러면서 GB stone 많아)=> 장세균이 이걸 urobilinogen으로 바꾸고 장에서 재흡수 => 혈중에서 녹아 있다가 콩팥으로 배출

PNH 는 왜 오나? 증상
밤에 산소수치가 떨어져서 acidosis 살짤 오면 그게 trigger인거임. ㅎㅎ
Paroxysmal nocturnal hemoglobinuria
Pancytopenia
N눅진한 피- venous thrombotic
H Hemolysis anemia…
PNH의 특징?
intravascular hemolysis
1. 지푸라기- venous thrombosis
2. hematuria
3. 팬에 룸서비스 pancytopenia - complement가 RBC만 공격하는게 아니지.

sickle cell dz the most accurate test?
HbS rather than HbA 그래서 electrophoresis

sickle cell dz 에서 spleen sequestration 이 만드는 RBC smear 에서의 변화와 취할조치?
하우~~우우우우 우~~~ Howell jolly body 가 spleem에 의해 제거되지 않고 출현 => 하울링하는 개에서 목줄에 퍼플 점
아저씨가 pencile들고 있지 페니실린 penicillin prophylaxis is recommended in early childhood
vaccination for encapsulated bacteria in childhood is critical (Strep pneumoniae, Neisseria meningitidis, Haemophilus influenzae)

parvo virus infection 이 큰 문제가 되는 질병군?
sickle cell 에서 a plastic anemia 가…

환자는 congenital hereditary spherocytosis 가 분명히 있는 적이 없는데 PB에 spheroyte가 보인다? Coomb test +
autoimmune hemolytic anemia 에서 발생 가능


이 mixed cryoglobulinemia 는 small vessel vasculitis이다. autoimmune hemolytic anemia랑 전혀 다른 거다.

HCV 가 있을때 그놈에 대한 항체에 대해서 IgM이 저온에서 뭉쳐서 small vessel vasculitis 만든다
nephropathy/ neuropathy / purpura
AIHA 에서 cold는 어떤 증상을 만드나
손이 파래짐. - 꼭 레이노드 처럼 추운 날에 손발에 혈관이 막힘 - IgM인데 이게 보면 저기 덩어리를 형성해서 막아버림.
+ anemia

Warm AIHA 에서 증상?
그냥 IgG가 터뜨림. anemia

AIHA 가 Extravascular hemolysis 게 아니면 intra 이게?
음식 공장 위에 둥그런 물탱크 있지.
spherocyte가 되므로 자연히 mostly extravascular 이다.
하지만 바로 터지기도 하므로 조금은 intravascular

AIHA test?
Direct Coombs’ test : 모든 ab에 결합하는 ab를 붙여서 agglutin 형성하면 양성









































































































